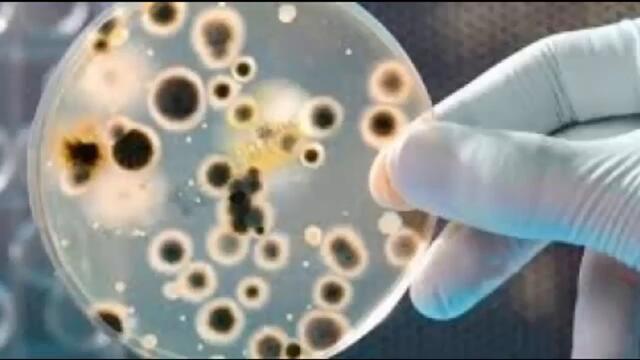

Гледай Кой е Игнац Земелвайс научаваме с Гугъл! Хигиенните порядки на Игнац Земелвайс Ignaz Semmelweis, видео качено от mentos, във Videoclip.bg - видео споделяне за всички българи!
Кой е Игнац Земелвайс научаваме с Гугъл! Хигиенните порядки на Игнац Земелвайс Ignaz Semmelweis - Videoclip.bg